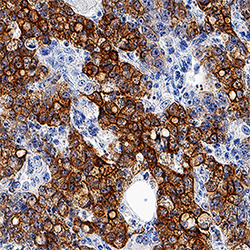

Antibody data
- Antibody Data
- Antigen structure
- References [1]
- Comments [0]
- Validations
- Immunocytochemistry [1]
- Immunohistochemistry [1]
Submit
Validation data
Reference
Comment
Report error
- Product number
- MAB3165 - Provider product page

- Provider
- R&D Systems
- Product name
- Human Cytokeratin 8 Antibody
- Antibody type
- Monoclonal
- Description
- Protein A or G purified from hybridoma culture supernatant. Detects human Cytokeratin 8.
- Reactivity
- Human
- Host
- Mouse
- Conjugate
- Unconjugated
- Isotype
- IgG
- Antibody clone number
- LP3K
- Vial size
- 100 ug
- Concentration
- LYOPH
- Storage
- Use a manual defrost freezer and avoid repeated freeze-thaw cycles. 12 months from date of receipt, -20 to -70 °C as supplied. 1 month, 2 to 8 °C under sterile conditions after reconstitution. 6 months, -20 to -70 °C under sterile conditions after reconstitution.
Submitted references TGFβ1 in fibroblasts-derived exosomes promotes epithelial-mesenchymal transition of ovarian cancer cells.
Li W, Zhang X, Wang J, Li M, Cao C, Tan J, Ma D, Gao Q
Oncotarget 2017 Nov 10;8(56):96035-96047
Oncotarget 2017 Nov 10;8(56):96035-96047
No comments: Submit comment
Supportive validation
- Submitted by
- R&D Systems (provider)
- Main image

- Experimental details
- Cytokeratin 8 in MCF-7 Human Cell Line. Cytokeratin 8 was detected in immersion fixed MCF-7 human breast cancer cell line using Mouse Anti-Human Cytokeratin 8 Monoclonal Antibody (Catalog # MAB3165) at 25 µg/mL for 3 hours at room temperature. Cells were stained using the NorthernLights™ 557-conjugated Anti-Mouse IgG Secondary Antibody (red; Catalog # NL007) and counterstained with DAPI (blue). Specific staining was localized to cytoplasm. View our protocol for Fluorescent ICC Staining of Cells on Coverslips.
Supportive validation
- Submitted by
- R&D Systems (provider)
- Main image
- Experimental details
- Cytokeratin 8 in Human Colon Cancer Tissue. Cytokeratin 8 was detected in immersion fixed paraffin-embedded sections of human colon cancer tissue using Mouse Anti-Human Cytokeratin 8 Monoclonal Antibody (Catalog # MAB3165) at 1.7 µg/mL overnight at 4 °C. Tissue was stained using the Anti-Mouse HRP-DAB Cell & Tissue Staining Kit (brown; Catalog # CTS002) and counterstained with hematoxylin (blue). Specific staining was localized to plasma membranes. View our protocol for Chromogenic IHC Staining of Paraffin-embedded Tissue Sections.